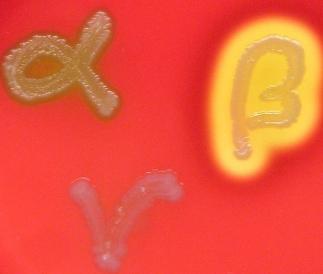

Publications:
http://www.ncbi.nlm.nih.gov/sites/myncbi/eric.brown.2/bibliography/40738471/public/?sort=date&direction=ascending
1. Jeevan, A., Denkins, Y., Brown, E.L., and Kripke, M.L. 1991. Effects of UV radiation on infectious disease In: Biologic Effects of Light. New York: Walter de Gruyter
& Company. pp 83-96.
2. Jeevan, A., Evans, R., Brown, E.L., and Kripke, M.L. 1992. Effect of local ultraviolet irradiation on infections of mice with Candida albicans, Mycobacterium bovis
BCG, and Schistosoma mansoni. J Invest Dermatol 99:59-64.
3. Jeevan, A., Brown, E.L., and Kripke, M.L. 1995. UV and Infectious Diseases. In Photoimmunology. J. Krutmann, and C. Elmets, editors. Cambridge: Blackwell
Science. pp 153-163.
4. Brown, E.L., Rivas, J.M., Ullrich, S.E., Young, C.R., Norris, S.J., and Kripke, M.L. 1995. Modulation of immunity to Borrelia burgdorferi by ultraviolet irradiation:
differential effect on Th1 and Th2 immune responses. Eur J Immunol 25:3017-3022.
5. Pride, M.W., Brown, E.L., Stephens, L.C., Killion, J.J., Norris, S.J., and Kripke, M.L. 1998. Specific Th1 cell lines that confer protective immunity against
experimental Borrelia burgdorferi infection in mice. J Leukoc Biol 63:542-549.
6. Guo, B.P., Brown, E.L., Dorward, D.W., Rosenberg, L.C., and Höök, M. 1998. Decorin-binding adhesins from Borrelia burgdorferi. Mol Microbiol 30:711-723.
7. Brown, E.L., Guo, B.P., O'Neal, P., and Höök, M. 1999. Adherence of Borrelia burgdorferi. Identification of critical lysine residues in DbpA required for decorin
binding. J Biol Chem 274:26272-26278.
8. Brown, E.L., Wooten, R.M., Johnson, B.J., Iozzo, R.V., Smith, A., Dolan, M.C., Guo, B.P., Weis, J.J., and Höök, M. 2001. Resistance to Lyme disease in decorin-
deficient mice. J Clin Invest 107:845-852.
9. Brown, E.L., Ullrich, S.E., Pride, M., and Kripke, M.L. 2001. The effect of UV irradiation on infection of mice with Borrelia burgdorferi. Photochem Photobiol 73:537-
544.
10. Cooper, D., Pride, M.W., Brown, E.L., Risin, D., and Pellis, N.R. 2001. Suppression of antigen-specific lymphocyte activation in modeled microgravity. In Vitro Cell
Dev Biol Anim 37:63-65.
11. Lee, L.Y., Miyamoto, Y.J., McIntyre, B.W., Höök, M., McCrea, K.W., McDevitt, D., and Brown, E.L. 2002. The Staphylococcus aureus Map protein is an
immunomodulator that interferes with T cell-mediated responses. J Clin Invest 110:1461-1471.
12. Pikas, D.S., Brown, E.L., Gurusiddappa, S., Lee, L.Y., Xu, Y., and Höök, M. 2003. Decorin-binding sites in the adhesin DbpA from Borrelia burgdorferi: a synthetic
peptide approach. J Biol Chem 278:30920-30926.
13. Willett, T.A., Meyer, A.L., Brown, E.L., and Huber, B.T. 2004. An effective second-generation outer surface protein A-derived Lyme vaccine that eliminates a
potentially autoreactive T cell epitope. Proc Natl Acad Sci USA 101:1303-1308.
14. Xu, Y., Rivas, J.M., Brown, E.L., Liang, X., and Höök, M. 2004. Virulence potential of the Staphylococcal adhesin CNA in experimental arthritis is determined by
its affinity for collagen. J Infect Dis 189:2323-2333.
15. Lee, L.Y., Höök, M., Haviland, D., Wetsel, R.A., Yonter, E.O., Syribeys, P., Vernachio, J., and Brown, E.L. 2004. A secreted Staphylococcus aureus protein inhibits
complement activation. J Infect Dis 190:571-579.
16. Liang, F.T., Brown, E.L., Wang, T., Iozzo, R.V., and Fikrig, E. 2004. Protective niche for Borrelia burgdorferi to evade humoral immunity. Am J Pathol 165:977-985.
17. Lee, L.Y., Liang, X., Hook, M., and Brown, E.L. 2004. Identification and characterization of the C3 binding domain of the Staphylococcus aureus extracellular
fibrinogen-binding protein (Efb). J Biol Chem 279:50710-50716.
18. Brown, E.L., Reisenbichler, E.S., Kim, J.-H., and Höök, M. 2005. Multicomponent Lyme vaccine: three is not a crowd. Vaccine 23:3687-3696.
19. Ochoa, T.J., Brown, E.L., Guion, C.E., Chen, J.Z., McMahon, R.J., and Cleary, T.G. 2006. Effect of lactoferrin on Enteroaggregative E. coli (EAEC). Biochem Cell
Biol 84:369-376.
20. Jarvelainen, H., Puolakkainen, P., Pakkanen, S., Brown, E.L., Höök, M., Iozzo, R.V., Sage, E.H., and Wight, T.N. 2006. A role for decorin in cutaneous wound
healing and angiogenesis. Wound Repair Regen 14:443-452.
21. Labandeira-Rey, M., Couzon, F., Boisset, S., Brown, E.L., Bes, M., Benito, Y., Barbu, E.M., Vazquez, V., Höök, M., M., Etienne, J., et al. 2007. Staphylococcus
aureus Panton-Valentine leukocidin causes necrotizing pneumonia. Science 315:1082-1085.
22. Massey, R.C., Scriba, T.J., Brown, E.L., Phillips, R.E., and Sewell, A.K. 2007. Use of peptide-major histocompatibility complex tetramer technology to study
interactions between Staphylococcus aureus proteins and human cells. Infect Immun 75:5711-5715.
23. Scriba, T.J., Sierro, S., Brown, E.L., Phillips, R.E., Sewell, A.K., and Massey, R.C. 2008. The S. aureus Eap protein activates expression of proinflammatory
cytokines. Infect Immun 76(5):2164-8.
24. Koo, H.L., Jiang, Z.D., Brown, E.L., Garcia, C., Qi, H., and DuPont, H.L. 2008. Coliform contamination of vegetables obtained from popular restaurants in
Guadalajara, Mexico, and Houston, Texas. Clin Infect Dis 47:218-221.
25. Huang, D.B., Brown, E.L., DuPont, H.L., Cerf, J., Carlin, L., Flores, J., Belkind-Gerson, J., Nataro, J.P., and Okhuysen, P.C. 2008. Seroprevalence of the
enteroaggregative Escherichia coli virulence factor dispersin among USA travellers to Cuernavaca, Mexico: a pilot study. J Med Microbiol 57:476-479.
26. Brown, E.L., Bowden, M.G., Bryson, R.S., Hulten, K.G., Bordt, A.S., Forbes, A., and Kaplan, S.L. 2009. The Pediatric Antibody Response to Community-Acquired
Staphylococcus aureus Infection is Directed to the Panton Valentine Leukocidin. Clin Vaccine Immunol 16:139-141.
27. Brown, E.L., Dumitrescu, O., Thomas, D., Badiou, C., Koers, E.M., Choudhury, P., Vazquez, V., Etienne, J., Lina, G., Vandenesch, F., and Bowden, M.G. 2009. The
Panton-Valentine leukocidin vaccine protects mice against lung and skin infections caused by Staphylococcus aureus USA300. Clin Microbiol Infect 15:156-164.
28. Vigil K.J., Jiang Z.D., Chen J.J., Palumbo K.L., Galbadage T., Brown E.L., Yiang J. Koo H., DuPont M.W., Ericsson C., Adachi J.A., DuPont H.L. Coliform and
Escherichia coli contamination of desserts served in public restaurants from Guadalajara, Mexico, and Houston, Texas. 2009. Am J Trop Med Hyg 80(4):606-608.
29. Brown, E.L., Xue, Q., Jiang, Z., DuPont, H.L. Pretreatment of epithelial cells with Rifaximin alters bacterial attachment and internalization profiles. 2010.
Antimicrobial Agents and Chemotherapy 54:388-396.
30. Vandenesch F., Couzon F., Boisset S., Benito Y., Brown E.L., Lina G., Etienne J., and Bowden, M.G. The Panton-Valentiine leukocidin is a virulence factor in a
murine model of necrotizing pneumonia. 2010. J. Infect. Dis. 201:967-969.
31. Jiang Z.D., DuPont H.L., Brown E.L., Nandy R.K., Ramamurthy T., Sinha A., Ghosh S., Guin S., Gurleen K., Rodrigues S., Chen J.J., McKenzie R., Steffen R.
Microbial Etiology of Travelers' Diarrhea in Mexico, Guatemala and India Importance of Enterotoxigenic Bacteroides fragilis and Arcobacter Species. 2010. J. Clin.
Microbiol. 48:1417-1419.
32. Espinoza, C., Fisher V., Jean W., Gaines B., Davis K, Wanger A., Brown E., Slomka J., Ostrosky-Zeichner L. Prevalence and risk factors of methicillin-resistant
Staphylococcus aureus colonization among critically ill hospitalized patients in a tertiary care center in Houston, Texas: An active surveillance pilot project. 2011.
Infect. Cont. Hosp. Epidemiol. 32:93-95.
33. Shah, D.P., Grimes, C.Z., Brown, E., Hwang, L. Demographics, socio-behaviorl factors, and drug use patterns: What matters in spontaneous HCV clearance.
2012. J. Med. Virol. 84:235-241.
34. Nichols, E.K., Nichols, J.S., Selwyn, B.J., Coello-Gomez, C., Parkerson, G.R., Brown, E.L., Day, R.S. Implications of the WHO Child Growth Standards in rural
Honduras. 2012. Public Health Nutr. 17:1-8.
35. Rudkin J.K., Edwards A.M., Bowden M.G., Brown, E.L., Pozzi C., Waters E.M. Chan W.C., Williams P., O'Gara J.P. and Massey, R. Methicillin resistance reduces
the virulence of healthcare-associated methicillin-resistant Staphylococcus aureus by interfering with the agr quorum sensing system. 2012. J. Infect. Dis. 205798-
806. PMID: 22301683.
36. Brown, E.L., NIshiyama, Y., Dunkle, J.W., Aggarwal, S., Planque, S., Watanabe, K., Smith, K.C., Bowden, M.G., Kaplan, S.L., Paul, S. Constitutive production of
catalytic antibodies to a Staphylococcus aureus virulence factor and effect of infection. 2012. J. Biol. Chem. 287:9940-9951.
37. Edwards, E.M., Bowden, M.G., Brown, E.L., Laabel, M., Massey, R.C. Staphyloccus aureus extracellular adherence protein triggers TNF alpha release,
promoting attachment to endothelial cells via Protein A. 2012. PLoS One. 8:e43046.
38. Mathews, E.E., Brown, E.L., Martinez, P.J., Upasana, N., Burton, R.L., Fisher-Hoch, S.P., McCormick, J.B., and Mirza, S. Impaired function of antibodies to
pneumococcal surface Protein A and not to capsular polysaccharide in Mexican American adults withy type 2 diabetes mellitus. Clin. Vac. Immunol. 2012. 19:1360-
1369. PMID: 22761295.
39. Brown, E.L., Smith, K.C., and Bowden, M.G. Identification of a T-cell epitope in the Staphylococcus aureus Panton-Valentine LukS-PV component. Open J.
Immunol. 2012. 3:111-115. DOI: 10.4236/oji.2012.23013.
40. Grimes, C.Z., Hwang, L., Wei, P., Shah, D.P., Volcik, K.A., and Brown, E.L. Differentially regulated gene expression associated with hepatitis C viral clearance. J.
Gen. Virol. 2013. Vol 94:534-542.
41. Schrodt C., McHugh E.E., Gawinowicz M., DuPont H.L., and Brown, E.L. Rifaximin-mediated changes to the epithelial cell proteome: 2-D gel analysis. 2013.
PLoS1 Vol 8: e68550.
42. Mathews, E.E., Actor, J., Brown, E.L., Martinez, P.J., Perla, J., Upasana, N., Hwang, S., Fisher-Hoch, S.P., McCormick, J.B., and Mirza, S. Impaired CD4+Th17
memory response to Streptococcus pneumoniae is associated with elevated glucose and %A1c in Mexican Americans with Type 2-diabetes. Translational Research.
S1931-5244 (13) 00213-2. doi:10.1016/j.trsl.2013.07.005. 2013.
43. Darkoh, C., Brown, E.L., Kaplan, H.B., and DuPont, H.L. Bile Salt Inhibition of Host Cell Damage by Clostridium difficile Toxins. PLoS1. 8:e79631. 2013.
44. Planque, S.A., Nishiyama, Y., Hara, M., Sonoda, S., Murphy, S.K., Watanabe, K., Mitsuda,Y., Brown, E.L., Massey, R.J., Primmer, S.R., O'Nuallain, B., and Paul, S.
Physiological Transthyretin Amyloid-Selective Catalytic Antibodies. J. Biol. Chem. 289: 13243-13258. 2014.
45. Gamble, R.K., Emery, R.J., Whitehead, L.W., Brown, E.L., and Flores R. The Feasibility of Using a Rapid Adenosine Triphosphate Bioluminescence Assay as an
Objective Means of Assessing the Presence of Biological Contamination on Laboratory Surfaces. Applied Biosafety. 19:141-148. 2014.
46. Leung, N.S., Padgett, P., Robinson, D.A., and Brown, E.L. Prevalence and behavioral risk factors of Staphylococcus aureus nasal colonization in community-
based injection drug users. Epi Infect. 2014. DOI: http://dx.doi.org/10.1017/S0950268814003227
47. Patlovich, S.J., Emery, R.J., Whitehead, L.W., Brown, E.L., and Flores, R. Assessing the Biological Safety Profession’s Evaluation and Control of Risks
Associated with the Field Collection of Potentially Infectious Specimens Applied Biosafety: Journal of the American Biological Safety. 2015.
48. Grzywa, R., Wlaczak, M., Lupicka-Slowik A., Bobrek, K., Boivin, S., Brown, E.L., Gawel, A., Stefaniak T., Oleksyszyn, J., Sienczyk, M. Adjuvant-dependent
immunogenicity of Staphylococcus aureus Efb and Map proteins in chickens. Vet Immunol Immunopathol. 2015. In press. doi:10.1016/j.vetimm.2015.04.009
49. Walczak, M., Grzywa, R., Lupicka-Slowik, A., Skorenski, M., Bobrek, K., Nowak, D., Boivin, S., Brown, E.L., Oleksyszyn, J., Sienczyk, M. Method for generation of
peptide-specific IgY antibodies directed to the Staphylococcus aureus exatracellular fibrinogen binding epitope. Biopolymers. 2015. doi:10.1002/bip.22695.
50. Brown, E.L., Below, J.E., Fischer, R.S., Essigmann, H.T., Hu, H., Huff, C., Robinson, A.D., Petty, L.E., Aguilar, D., Bell, G.I., Hanis, C.L. Genome-wide association
study of Staphylococcus aureus nasal carriage in a community-based sample of Mexican-Americans in Starr County, Texas. PLoS1. DOI: 10.1371/journal.pone.
0142130. 2015
51. Hanis, C.L, Redline, S., Cade, B.E., Bell, G.I., Cox, N.J., Below, J.E., Brown, E.L., Aguilar, D. Beyond Type 2 Diabetes, Obesity and Hypertension: An Axis Including
Sleep Apnea, Left Ventricular Hypertrophy, Endothelial Dysfunction, and Aortic Stiffness among Mexican Americans in Starr County, Texas. Cardiovasc. Diabetol. 15:
86. DOI 10.1186/s12933-016-0405-6. 2016.
52. Tolo, I., Thomas, J.C., Fischer, R.S., Brown, E.L., B.M. Gray, D.A. Robinson. Do Staphylococcus epidermidis genetic clusters predict isolation sources? J. Clin.
Microbiol. 7:1711-1719. DOI:10.1128/JCM.03345-15. 2016.
53. Gunter, G.M., Jones, K.M., Zhan, B., Essigmann, H.T., Murray, K.O., Garcia, M.N., Gorchakov, R., Botazi, M.E., Hotez, P.J., Brown, E.L. Identification and
characterization of the Trypanosoma cruzi B-cell superantigen Tc24. Am. J. Trop. Med. Hyg. 2016.94:114-121 DOI: 10.4269/ajtmh.15-0438. 2016.
54. Agarwal, S., Nguyen D.T., Lew, J., Teeter, L.D., Yamal, J.M., Restrepo, B., Brown, E.L., Dorman, S., Graviss, E.A. Comparing TSPOT Assay Results between an
Elispot Reader and Manual Counts. Tuberculosis. 101:S92-S98. PMID 27727132. 2016.
55. Agarwal, S., Nguyen D.T., Lew, J., Teeter, L.D., Yamal, J.M., Restrepo, B., Brown, E.L., Dorman, S., Graviss, E.A. Differential Positive TSPOT Assay Responses to
ESAT-6 and CFP-10 in Health Care Workers. Tuberculosis. 101:S83-S91. PMID: 27727133. 2016.
56. Reid, M., Fischer, R., Mannathoko, N., Muthoga, C., McHugh, E., Essigmann, H.T., Brown, E.L., and Steenhoff, A. Prevalence of Staphylococcus aureus nasal
carriage in HIV-infected and HIV-uninfected children in Botswana. Am. J. Trop. Med. Hyg. In Press.
57. Gunter, S.L., Brown, E.L., Gorchakov, R., Murray, K.O., and Garcia, M.N. Sylvatic transmission of Trypanosoma cruzi among domestic and wildlife reservoirs in
Texas, USA: A review of the historical literature. Zoonoses and Public Health. 2016. DOI: 10.1111/zph.12330. PMID:27911051. 2016.
58. Mahale, P., Torres, H.A., Kramer, J.R., Hwang L., Li, R., Brown, E.L., and Engels, E.A. Hepatitis C virus infection and the risk of cancer among elderly US adults:
A registry-based case-control study. Cancer. doi:10.1002/cncr.30559. PMID:28117886. 2017.
59. Essigmann, H.T., Darkoh, C., McHugh, E.E., and Brown, E.L. The Clostridium difficile quorum-sensing molecule alters the Staphylococcus aureus toxin
expression profile. Int. J. Antimicrobiol. Ag. http://dx.doi.org/10.1016/j.ijantimicag.2017.01.001. PMID:28111286. 2017.
60. M.J Reid, A.P. Steenhoff, N. Mannathoko, C. Muthoga, E. McHugh, E.L. Brown, and R.S. Fischer. Staphylococcus aureus nasal colonization among
HIV- infected adults in Botswana: Prevalence and risk factors. AIDS Care. 2017. PMID: 28127988.
61. Gunter, S.M., Murray, K.O., Gorchakov. R., Beddard. R., Rossmann. S.N., Montgomery, S.P., Rivera, H., Brown, E.L., Aguilar, D., Widman, L.E., Garcia, M.N. Likely
autochthonous transmission of T. cruzi to humans, Southcentral Texas, USA. Emerging infectious diseases. 2017. 23(3):494-497. doi:10.3201/eid2303.161157.
62 A.G. Nyitray, J.T. Hicks, L.Y. Hwang, S. Baraniuk, M. White, S. Millas, N. Onwuka, X. Zhang, E.L. Brown, M.W. Ross, E.Y. Chiao. A Phase 2 clinical study to assess
the feasibility of self- and partner anal exams to detect anal canal abnormalities including anal cancer. Sex. Transm. Infect. 2017. PMID: 28835533.
63. N.S. Leung, M.L. Vidoni, D.A. Robinson, P. Padgett, and E.L. Brown. A Community-based study of Staphylococcus aureus nasal colonization and molecular
characterization among men who have sex with men. LGBT Health. 5:345-351. 2017. PMID: 29022859.
64. P. Mahale, E.A. Engles, L. Ruosha, H. Torres, L.Y. Hwang, E.L. Brown, and J. Kramer. The effect of sustained virological response on the risk of extrahepatic
manifestations of hepatitis C virus infection. Gut. 2017. PMID: 28634198.
65. S.M. Gunter, K.M. Jones, C.A. Seid, H.T. Essigmann, B. Zhan, U. Strych, M.E. Bottazzi, P.J. Hotez, and E.L. Brown. Mutations to cysteine residues in the
Trypanosoma cruzi B-cell superantigen Tc24 diminish susceptibility to IgM-mediated hydrolysis. J. Parasitol. 2017. PMID: 28581897.
66. H.L. Hanis, K. Garrett, H.T. Essigmann, D.A. Robinson, S.M. Gunter, A.G. Nyitray, and E.L. Brown. Household aggregation of Staphylococcus aureus by clonal
complex and methicillin resistance profiles in Starr County, Texas. Eur. J. Clin. Microbiol. Infect. Dis. 36: 1787-1793. 2017. PMID: 28474178.
67. M.S. Nolan, D. Agular, E.L. Brown, S.M. Gunter, S.E. Ronca, C.L. Hanis, and K.O. Murray. Continuing evidence of human Chagas disease along the Texas-Mexico
border. PLOS Neglected Tropical Diseases. 2018.12(11): e0006899. https://doi.org/10.1371/journal. pntd.0006899. PMID: 304427833.
68. Sarah M. Gunter, Leroy Versteeg, Kathryn M. Jones, Brian P. Keegan, Ulrich Strych, Maria Elena Bottazzi, Peter J. Hotez, and E.L. Brown. Covalent vaccination
with Trypanosoma cruzi Tc24 induces catalytic antibody production. Parasite Immunol. 2018. 40(11):e12585. doi: 10.1111/pim.12585. PMID: 30132929.
69. S.M. Gunter, C. Cordray, R. Gorchakov, I. Du, B. Dittmar, E.L. Brown, K. Murray, and M. Nolan Garcia. Identification of white-tailed deer (Odocoileus virginianus)
as a novel reservoir species for Trypanososma cruzi in Texas. J. Wildlife Dis. 2018. 54(4):814-818. doi:10.7589/2017-09-223. PMID: 29889005.
70. L. Challagundla, X. Luo, I.A. Tickler, X. Didelot, D.C. Coleman, A.C. Shore, G.W. Coombs, D.O. Sordelli, E.L. Brown, R. Skov, A.R. Larsen, J. Reyes, I.E. Robledo, G.J.
Vazquez, R. Rivera, P.D. Fey, K. Stevenson, S.H. Wang, B.N. Kreiswirth, J.R. Mediavilla, C.A. Arias, P.J. Planet, R.L. Nolan, F.C. Tenover, R.V. Goering, D.A. Robinson.
Range Expansion and the Origin of USA300 North American Epidemic Methicillin-Resistant Staphylococcus aureus. MBio. 2018. Jan-Feb; 9(1): e02016-17. PMID:
29295910.
http://www.ncbi.nlm.nih.gov/sites/myncbi/eric.brown.2/bibliography/40738471/public/?sort=date&direction=ascending
1. Jeevan, A., Denkins, Y., Brown, E.L., and Kripke, M.L. 1991. Effects of UV radiation on infectious disease In: Biologic Effects of Light. New York: Walter de Gruyter
& Company. pp 83-96.
2. Jeevan, A., Evans, R., Brown, E.L., and Kripke, M.L. 1992. Effect of local ultraviolet irradiation on infections of mice with Candida albicans, Mycobacterium bovis
BCG, and Schistosoma mansoni. J Invest Dermatol 99:59-64.
3. Jeevan, A., Brown, E.L., and Kripke, M.L. 1995. UV and Infectious Diseases. In Photoimmunology. J. Krutmann, and C. Elmets, editors. Cambridge: Blackwell
Science. pp 153-163.
4. Brown, E.L., Rivas, J.M., Ullrich, S.E., Young, C.R., Norris, S.J., and Kripke, M.L. 1995. Modulation of immunity to Borrelia burgdorferi by ultraviolet irradiation:
differential effect on Th1 and Th2 immune responses. Eur J Immunol 25:3017-3022.
5. Pride, M.W., Brown, E.L., Stephens, L.C., Killion, J.J., Norris, S.J., and Kripke, M.L. 1998. Specific Th1 cell lines that confer protective immunity against
experimental Borrelia burgdorferi infection in mice. J Leukoc Biol 63:542-549.
6. Guo, B.P., Brown, E.L., Dorward, D.W., Rosenberg, L.C., and Höök, M. 1998. Decorin-binding adhesins from Borrelia burgdorferi. Mol Microbiol 30:711-723.
7. Brown, E.L., Guo, B.P., O'Neal, P., and Höök, M. 1999. Adherence of Borrelia burgdorferi. Identification of critical lysine residues in DbpA required for decorin
binding. J Biol Chem 274:26272-26278.
8. Brown, E.L., Wooten, R.M., Johnson, B.J., Iozzo, R.V., Smith, A., Dolan, M.C., Guo, B.P., Weis, J.J., and Höök, M. 2001. Resistance to Lyme disease in decorin-
deficient mice. J Clin Invest 107:845-852.
9. Brown, E.L., Ullrich, S.E., Pride, M., and Kripke, M.L. 2001. The effect of UV irradiation on infection of mice with Borrelia burgdorferi. Photochem Photobiol 73:537-
544.
10. Cooper, D., Pride, M.W., Brown, E.L., Risin, D., and Pellis, N.R. 2001. Suppression of antigen-specific lymphocyte activation in modeled microgravity. In Vitro Cell
Dev Biol Anim 37:63-65.
11. Lee, L.Y., Miyamoto, Y.J., McIntyre, B.W., Höök, M., McCrea, K.W., McDevitt, D., and Brown, E.L. 2002. The Staphylococcus aureus Map protein is an
immunomodulator that interferes with T cell-mediated responses. J Clin Invest 110:1461-1471.
12. Pikas, D.S., Brown, E.L., Gurusiddappa, S., Lee, L.Y., Xu, Y., and Höök, M. 2003. Decorin-binding sites in the adhesin DbpA from Borrelia burgdorferi: a synthetic
peptide approach. J Biol Chem 278:30920-30926.
13. Willett, T.A., Meyer, A.L., Brown, E.L., and Huber, B.T. 2004. An effective second-generation outer surface protein A-derived Lyme vaccine that eliminates a
potentially autoreactive T cell epitope. Proc Natl Acad Sci USA 101:1303-1308.
14. Xu, Y., Rivas, J.M., Brown, E.L., Liang, X., and Höök, M. 2004. Virulence potential of the Staphylococcal adhesin CNA in experimental arthritis is determined by
its affinity for collagen. J Infect Dis 189:2323-2333.
15. Lee, L.Y., Höök, M., Haviland, D., Wetsel, R.A., Yonter, E.O., Syribeys, P., Vernachio, J., and Brown, E.L. 2004. A secreted Staphylococcus aureus protein inhibits
complement activation. J Infect Dis 190:571-579.
16. Liang, F.T., Brown, E.L., Wang, T., Iozzo, R.V., and Fikrig, E. 2004. Protective niche for Borrelia burgdorferi to evade humoral immunity. Am J Pathol 165:977-985.
17. Lee, L.Y., Liang, X., Hook, M., and Brown, E.L. 2004. Identification and characterization of the C3 binding domain of the Staphylococcus aureus extracellular
fibrinogen-binding protein (Efb). J Biol Chem 279:50710-50716.
18. Brown, E.L., Reisenbichler, E.S., Kim, J.-H., and Höök, M. 2005. Multicomponent Lyme vaccine: three is not a crowd. Vaccine 23:3687-3696.
19. Ochoa, T.J., Brown, E.L., Guion, C.E., Chen, J.Z., McMahon, R.J., and Cleary, T.G. 2006. Effect of lactoferrin on Enteroaggregative E. coli (EAEC). Biochem Cell
Biol 84:369-376.
20. Jarvelainen, H., Puolakkainen, P., Pakkanen, S., Brown, E.L., Höök, M., Iozzo, R.V., Sage, E.H., and Wight, T.N. 2006. A role for decorin in cutaneous wound
healing and angiogenesis. Wound Repair Regen 14:443-452.
21. Labandeira-Rey, M., Couzon, F., Boisset, S., Brown, E.L., Bes, M., Benito, Y., Barbu, E.M., Vazquez, V., Höök, M., M., Etienne, J., et al. 2007. Staphylococcus
aureus Panton-Valentine leukocidin causes necrotizing pneumonia. Science 315:1082-1085.
22. Massey, R.C., Scriba, T.J., Brown, E.L., Phillips, R.E., and Sewell, A.K. 2007. Use of peptide-major histocompatibility complex tetramer technology to study
interactions between Staphylococcus aureus proteins and human cells. Infect Immun 75:5711-5715.
23. Scriba, T.J., Sierro, S., Brown, E.L., Phillips, R.E., Sewell, A.K., and Massey, R.C. 2008. The S. aureus Eap protein activates expression of proinflammatory
cytokines. Infect Immun 76(5):2164-8.
24. Koo, H.L., Jiang, Z.D., Brown, E.L., Garcia, C., Qi, H., and DuPont, H.L. 2008. Coliform contamination of vegetables obtained from popular restaurants in
Guadalajara, Mexico, and Houston, Texas. Clin Infect Dis 47:218-221.
25. Huang, D.B., Brown, E.L., DuPont, H.L., Cerf, J., Carlin, L., Flores, J., Belkind-Gerson, J., Nataro, J.P., and Okhuysen, P.C. 2008. Seroprevalence of the
enteroaggregative Escherichia coli virulence factor dispersin among USA travellers to Cuernavaca, Mexico: a pilot study. J Med Microbiol 57:476-479.
26. Brown, E.L., Bowden, M.G., Bryson, R.S., Hulten, K.G., Bordt, A.S., Forbes, A., and Kaplan, S.L. 2009. The Pediatric Antibody Response to Community-Acquired
Staphylococcus aureus Infection is Directed to the Panton Valentine Leukocidin. Clin Vaccine Immunol 16:139-141.
27. Brown, E.L., Dumitrescu, O., Thomas, D., Badiou, C., Koers, E.M., Choudhury, P., Vazquez, V., Etienne, J., Lina, G., Vandenesch, F., and Bowden, M.G. 2009. The
Panton-Valentine leukocidin vaccine protects mice against lung and skin infections caused by Staphylococcus aureus USA300. Clin Microbiol Infect 15:156-164.
28. Vigil K.J., Jiang Z.D., Chen J.J., Palumbo K.L., Galbadage T., Brown E.L., Yiang J. Koo H., DuPont M.W., Ericsson C., Adachi J.A., DuPont H.L. Coliform and
Escherichia coli contamination of desserts served in public restaurants from Guadalajara, Mexico, and Houston, Texas. 2009. Am J Trop Med Hyg 80(4):606-608.
29. Brown, E.L., Xue, Q., Jiang, Z., DuPont, H.L. Pretreatment of epithelial cells with Rifaximin alters bacterial attachment and internalization profiles. 2010.
Antimicrobial Agents and Chemotherapy 54:388-396.
30. Vandenesch F., Couzon F., Boisset S., Benito Y., Brown E.L., Lina G., Etienne J., and Bowden, M.G. The Panton-Valentiine leukocidin is a virulence factor in a
murine model of necrotizing pneumonia. 2010. J. Infect. Dis. 201:967-969.
31. Jiang Z.D., DuPont H.L., Brown E.L., Nandy R.K., Ramamurthy T., Sinha A., Ghosh S., Guin S., Gurleen K., Rodrigues S., Chen J.J., McKenzie R., Steffen R.
Microbial Etiology of Travelers' Diarrhea in Mexico, Guatemala and India Importance of Enterotoxigenic Bacteroides fragilis and Arcobacter Species. 2010. J. Clin.
Microbiol. 48:1417-1419.
32. Espinoza, C., Fisher V., Jean W., Gaines B., Davis K, Wanger A., Brown E., Slomka J., Ostrosky-Zeichner L. Prevalence and risk factors of methicillin-resistant
Staphylococcus aureus colonization among critically ill hospitalized patients in a tertiary care center in Houston, Texas: An active surveillance pilot project. 2011.
Infect. Cont. Hosp. Epidemiol. 32:93-95.
33. Shah, D.P., Grimes, C.Z., Brown, E., Hwang, L. Demographics, socio-behaviorl factors, and drug use patterns: What matters in spontaneous HCV clearance.
2012. J. Med. Virol. 84:235-241.
34. Nichols, E.K., Nichols, J.S., Selwyn, B.J., Coello-Gomez, C., Parkerson, G.R., Brown, E.L., Day, R.S. Implications of the WHO Child Growth Standards in rural
Honduras. 2012. Public Health Nutr. 17:1-8.
35. Rudkin J.K., Edwards A.M., Bowden M.G., Brown, E.L., Pozzi C., Waters E.M. Chan W.C., Williams P., O'Gara J.P. and Massey, R. Methicillin resistance reduces
the virulence of healthcare-associated methicillin-resistant Staphylococcus aureus by interfering with the agr quorum sensing system. 2012. J. Infect. Dis. 205798-
806. PMID: 22301683.
36. Brown, E.L., NIshiyama, Y., Dunkle, J.W., Aggarwal, S., Planque, S., Watanabe, K., Smith, K.C., Bowden, M.G., Kaplan, S.L., Paul, S. Constitutive production of
catalytic antibodies to a Staphylococcus aureus virulence factor and effect of infection. 2012. J. Biol. Chem. 287:9940-9951.
37. Edwards, E.M., Bowden, M.G., Brown, E.L., Laabel, M., Massey, R.C. Staphyloccus aureus extracellular adherence protein triggers TNF alpha release,
promoting attachment to endothelial cells via Protein A. 2012. PLoS One. 8:e43046.
38. Mathews, E.E., Brown, E.L., Martinez, P.J., Upasana, N., Burton, R.L., Fisher-Hoch, S.P., McCormick, J.B., and Mirza, S. Impaired function of antibodies to
pneumococcal surface Protein A and not to capsular polysaccharide in Mexican American adults withy type 2 diabetes mellitus. Clin. Vac. Immunol. 2012. 19:1360-
1369. PMID: 22761295.
39. Brown, E.L., Smith, K.C., and Bowden, M.G. Identification of a T-cell epitope in the Staphylococcus aureus Panton-Valentine LukS-PV component. Open J.
Immunol. 2012. 3:111-115. DOI: 10.4236/oji.2012.23013.
40. Grimes, C.Z., Hwang, L., Wei, P., Shah, D.P., Volcik, K.A., and Brown, E.L. Differentially regulated gene expression associated with hepatitis C viral clearance. J.
Gen. Virol. 2013. Vol 94:534-542.
41. Schrodt C., McHugh E.E., Gawinowicz M., DuPont H.L., and Brown, E.L. Rifaximin-mediated changes to the epithelial cell proteome: 2-D gel analysis. 2013.
PLoS1 Vol 8: e68550.
42. Mathews, E.E., Actor, J., Brown, E.L., Martinez, P.J., Perla, J., Upasana, N., Hwang, S., Fisher-Hoch, S.P., McCormick, J.B., and Mirza, S. Impaired CD4+Th17
memory response to Streptococcus pneumoniae is associated with elevated glucose and %A1c in Mexican Americans with Type 2-diabetes. Translational Research.
S1931-5244 (13) 00213-2. doi:10.1016/j.trsl.2013.07.005. 2013.
43. Darkoh, C., Brown, E.L., Kaplan, H.B., and DuPont, H.L. Bile Salt Inhibition of Host Cell Damage by Clostridium difficile Toxins. PLoS1. 8:e79631. 2013.
44. Planque, S.A., Nishiyama, Y., Hara, M., Sonoda, S., Murphy, S.K., Watanabe, K., Mitsuda,Y., Brown, E.L., Massey, R.J., Primmer, S.R., O'Nuallain, B., and Paul, S.
Physiological Transthyretin Amyloid-Selective Catalytic Antibodies. J. Biol. Chem. 289: 13243-13258. 2014.
45. Gamble, R.K., Emery, R.J., Whitehead, L.W., Brown, E.L., and Flores R. The Feasibility of Using a Rapid Adenosine Triphosphate Bioluminescence Assay as an
Objective Means of Assessing the Presence of Biological Contamination on Laboratory Surfaces. Applied Biosafety. 19:141-148. 2014.
46. Leung, N.S., Padgett, P., Robinson, D.A., and Brown, E.L. Prevalence and behavioral risk factors of Staphylococcus aureus nasal colonization in community-
based injection drug users. Epi Infect. 2014. DOI: http://dx.doi.org/10.1017/S0950268814003227
47. Patlovich, S.J., Emery, R.J., Whitehead, L.W., Brown, E.L., and Flores, R. Assessing the Biological Safety Profession’s Evaluation and Control of Risks
Associated with the Field Collection of Potentially Infectious Specimens Applied Biosafety: Journal of the American Biological Safety. 2015.
48. Grzywa, R., Wlaczak, M., Lupicka-Slowik A., Bobrek, K., Boivin, S., Brown, E.L., Gawel, A., Stefaniak T., Oleksyszyn, J., Sienczyk, M. Adjuvant-dependent
immunogenicity of Staphylococcus aureus Efb and Map proteins in chickens. Vet Immunol Immunopathol. 2015. In press. doi:10.1016/j.vetimm.2015.04.009
49. Walczak, M., Grzywa, R., Lupicka-Slowik, A., Skorenski, M., Bobrek, K., Nowak, D., Boivin, S., Brown, E.L., Oleksyszyn, J., Sienczyk, M. Method for generation of
peptide-specific IgY antibodies directed to the Staphylococcus aureus exatracellular fibrinogen binding epitope. Biopolymers. 2015. doi:10.1002/bip.22695.
50. Brown, E.L., Below, J.E., Fischer, R.S., Essigmann, H.T., Hu, H., Huff, C., Robinson, A.D., Petty, L.E., Aguilar, D., Bell, G.I., Hanis, C.L. Genome-wide association
study of Staphylococcus aureus nasal carriage in a community-based sample of Mexican-Americans in Starr County, Texas. PLoS1. DOI: 10.1371/journal.pone.
0142130. 2015
51. Hanis, C.L, Redline, S., Cade, B.E., Bell, G.I., Cox, N.J., Below, J.E., Brown, E.L., Aguilar, D. Beyond Type 2 Diabetes, Obesity and Hypertension: An Axis Including
Sleep Apnea, Left Ventricular Hypertrophy, Endothelial Dysfunction, and Aortic Stiffness among Mexican Americans in Starr County, Texas. Cardiovasc. Diabetol. 15:
86. DOI 10.1186/s12933-016-0405-6. 2016.
52. Tolo, I., Thomas, J.C., Fischer, R.S., Brown, E.L., B.M. Gray, D.A. Robinson. Do Staphylococcus epidermidis genetic clusters predict isolation sources? J. Clin.
Microbiol. 7:1711-1719. DOI:10.1128/JCM.03345-15. 2016.
53. Gunter, G.M., Jones, K.M., Zhan, B., Essigmann, H.T., Murray, K.O., Garcia, M.N., Gorchakov, R., Botazi, M.E., Hotez, P.J., Brown, E.L. Identification and
characterization of the Trypanosoma cruzi B-cell superantigen Tc24. Am. J. Trop. Med. Hyg. 2016.94:114-121 DOI: 10.4269/ajtmh.15-0438. 2016.
54. Agarwal, S., Nguyen D.T., Lew, J., Teeter, L.D., Yamal, J.M., Restrepo, B., Brown, E.L., Dorman, S., Graviss, E.A. Comparing TSPOT Assay Results between an
Elispot Reader and Manual Counts. Tuberculosis. 101:S92-S98. PMID 27727132. 2016.
55. Agarwal, S., Nguyen D.T., Lew, J., Teeter, L.D., Yamal, J.M., Restrepo, B., Brown, E.L., Dorman, S., Graviss, E.A. Differential Positive TSPOT Assay Responses to
ESAT-6 and CFP-10 in Health Care Workers. Tuberculosis. 101:S83-S91. PMID: 27727133. 2016.
56. Reid, M., Fischer, R., Mannathoko, N., Muthoga, C., McHugh, E., Essigmann, H.T., Brown, E.L., and Steenhoff, A. Prevalence of Staphylococcus aureus nasal
carriage in HIV-infected and HIV-uninfected children in Botswana. Am. J. Trop. Med. Hyg. In Press.
57. Gunter, S.L., Brown, E.L., Gorchakov, R., Murray, K.O., and Garcia, M.N. Sylvatic transmission of Trypanosoma cruzi among domestic and wildlife reservoirs in
Texas, USA: A review of the historical literature. Zoonoses and Public Health. 2016. DOI: 10.1111/zph.12330. PMID:27911051. 2016.
58. Mahale, P., Torres, H.A., Kramer, J.R., Hwang L., Li, R., Brown, E.L., and Engels, E.A. Hepatitis C virus infection and the risk of cancer among elderly US adults:
A registry-based case-control study. Cancer. doi:10.1002/cncr.30559. PMID:28117886. 2017.
59. Essigmann, H.T., Darkoh, C., McHugh, E.E., and Brown, E.L. The Clostridium difficile quorum-sensing molecule alters the Staphylococcus aureus toxin
expression profile. Int. J. Antimicrobiol. Ag. http://dx.doi.org/10.1016/j.ijantimicag.2017.01.001. PMID:28111286. 2017.
60. M.J Reid, A.P. Steenhoff, N. Mannathoko, C. Muthoga, E. McHugh, E.L. Brown, and R.S. Fischer. Staphylococcus aureus nasal colonization among
HIV- infected adults in Botswana: Prevalence and risk factors. AIDS Care. 2017. PMID: 28127988.
61. Gunter, S.M., Murray, K.O., Gorchakov. R., Beddard. R., Rossmann. S.N., Montgomery, S.P., Rivera, H., Brown, E.L., Aguilar, D., Widman, L.E., Garcia, M.N. Likely
autochthonous transmission of T. cruzi to humans, Southcentral Texas, USA. Emerging infectious diseases. 2017. 23(3):494-497. doi:10.3201/eid2303.161157.
62 A.G. Nyitray, J.T. Hicks, L.Y. Hwang, S. Baraniuk, M. White, S. Millas, N. Onwuka, X. Zhang, E.L. Brown, M.W. Ross, E.Y. Chiao. A Phase 2 clinical study to assess
the feasibility of self- and partner anal exams to detect anal canal abnormalities including anal cancer. Sex. Transm. Infect. 2017. PMID: 28835533.
63. N.S. Leung, M.L. Vidoni, D.A. Robinson, P. Padgett, and E.L. Brown. A Community-based study of Staphylococcus aureus nasal colonization and molecular
characterization among men who have sex with men. LGBT Health. 5:345-351. 2017. PMID: 29022859.
64. P. Mahale, E.A. Engles, L. Ruosha, H. Torres, L.Y. Hwang, E.L. Brown, and J. Kramer. The effect of sustained virological response on the risk of extrahepatic
manifestations of hepatitis C virus infection. Gut. 2017. PMID: 28634198.
65. S.M. Gunter, K.M. Jones, C.A. Seid, H.T. Essigmann, B. Zhan, U. Strych, M.E. Bottazzi, P.J. Hotez, and E.L. Brown. Mutations to cysteine residues in the
Trypanosoma cruzi B-cell superantigen Tc24 diminish susceptibility to IgM-mediated hydrolysis. J. Parasitol. 2017. PMID: 28581897.
66. H.L. Hanis, K. Garrett, H.T. Essigmann, D.A. Robinson, S.M. Gunter, A.G. Nyitray, and E.L. Brown. Household aggregation of Staphylococcus aureus by clonal
complex and methicillin resistance profiles in Starr County, Texas. Eur. J. Clin. Microbiol. Infect. Dis. 36: 1787-1793. 2017. PMID: 28474178.
67. M.S. Nolan, D. Agular, E.L. Brown, S.M. Gunter, S.E. Ronca, C.L. Hanis, and K.O. Murray. Continuing evidence of human Chagas disease along the Texas-Mexico
border. PLOS Neglected Tropical Diseases. 2018.12(11): e0006899. https://doi.org/10.1371/journal. pntd.0006899. PMID: 304427833.
68. Sarah M. Gunter, Leroy Versteeg, Kathryn M. Jones, Brian P. Keegan, Ulrich Strych, Maria Elena Bottazzi, Peter J. Hotez, and E.L. Brown. Covalent vaccination
with Trypanosoma cruzi Tc24 induces catalytic antibody production. Parasite Immunol. 2018. 40(11):e12585. doi: 10.1111/pim.12585. PMID: 30132929.
69. S.M. Gunter, C. Cordray, R. Gorchakov, I. Du, B. Dittmar, E.L. Brown, K. Murray, and M. Nolan Garcia. Identification of white-tailed deer (Odocoileus virginianus)
as a novel reservoir species for Trypanososma cruzi in Texas. J. Wildlife Dis. 2018. 54(4):814-818. doi:10.7589/2017-09-223. PMID: 29889005.
70. L. Challagundla, X. Luo, I.A. Tickler, X. Didelot, D.C. Coleman, A.C. Shore, G.W. Coombs, D.O. Sordelli, E.L. Brown, R. Skov, A.R. Larsen, J. Reyes, I.E. Robledo, G.J.
Vazquez, R. Rivera, P.D. Fey, K. Stevenson, S.H. Wang, B.N. Kreiswirth, J.R. Mediavilla, C.A. Arias, P.J. Planet, R.L. Nolan, F.C. Tenover, R.V. Goering, D.A. Robinson.
Range Expansion and the Origin of USA300 North American Epidemic Methicillin-Resistant Staphylococcus aureus. MBio. 2018. Jan-Feb; 9(1): e02016-17. PMID:
29295910.



| @doctorbrown_org This website provides research summaries of E.L. Brown's research projects, publications, lecture materials and laboratory protocols. |
| Summary of Research Interests: Staphylococcal research: -Vaccine design -Mechanisms of disease -Translational medicine |
Our research interests encompass various inter-related areas associated with the development of
treatment modalities for S. aureus and Trypanodoam cruzi infections including modification of the host
microbiome. Specifically we are interested in:
i) Understanding the mechanisms of disease.
ii) Testing vaccine candidates.
-Development of electrophilic vaccines designed to elicit antigen specific catalytic antibodies.
iii) Developing novel treatment modalities based on purified and recombinant anti-antibodies.
| DoctorBrown.org |

Custom Search
Last update: 2.14.19
"...and all this science I
don't understand, it's just
my job 5 7 days a week.'
Rocket Man, Elton John
don't understand, it's just
my job 5 7 days a week.'
Rocket Man, Elton John
-
